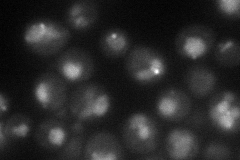
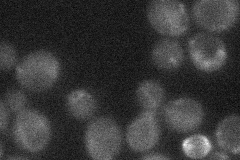
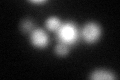

View description
Protein of unknown function, member of the DUP380 subfamily of conserved, often subtelomerically-encoded proteins
Localization:
Intensity:
Fold change:
Significance:
-
C’ GFP library in SD

vacuole27.27 -
N' NOP1pr-GFP in SD
vacuole46.7143 -
N' TEF2pr-mCherry in SD

vacuole49.527 -
N' NATIVEpr-GFP in SD
below threshold19.7049 -
N' TEF2pr-VC and Cyto-VN in SD

below threshold24.7292 -
C’ GFP library in SD+DTT
vacuole45.851.68Yes -
C’ GFP library in SD+H2O2

vacuole19.150.7Yes -
C’ GFP library in Starvation Media

vacuole32.151.17No -
C’ GFP library on the background of Pup2-DaMP

vacuole -
C’ GFP library on the background of CCT mutant

vacuole20.53830.752967No
